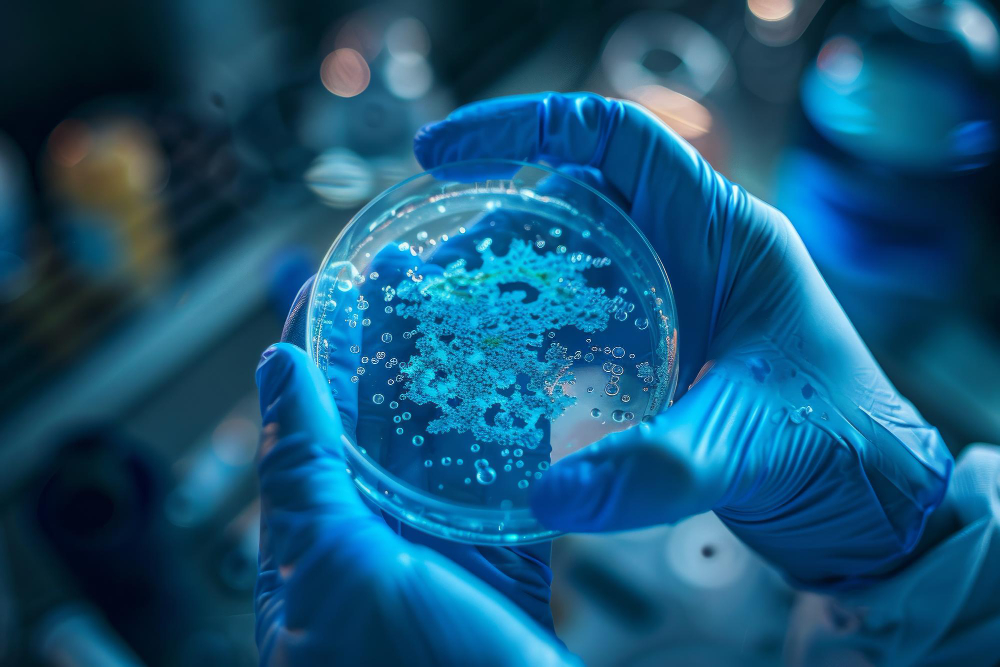
Microbiology Testing

Accurate, reliable, and timely laboratory testing for healthcare providers and patients.
Aivanta Labs LLC provides advanced clinical laboratory services supported by modern technology, experienced professionals, and strict quality standards to ensure precise and dependable results.
Comprehensive blood analysis including Complete Blood Count (CBC), anemia screening, and clotting studies to detect infections and blood disorders with accuracy.

Testing for glucose levels, liver and kidney function, lipid profiles, and metabolic panels to support accurate diagnosis and chronic disease management.

Identification and analysis of bacterial, viral, and fungal infections to support accurate diagnosis and targeted treatment strategies.
Advanced PCR-based and genetic testing services enabling early detection of infectious diseases and specialized diagnostic needs.

Whether you need the right lab solution, support on an order, or want to partner with us — we’re just a message away.
High-Quality Lab Products • Trusted by Pharma & Research • Backed by Expertise